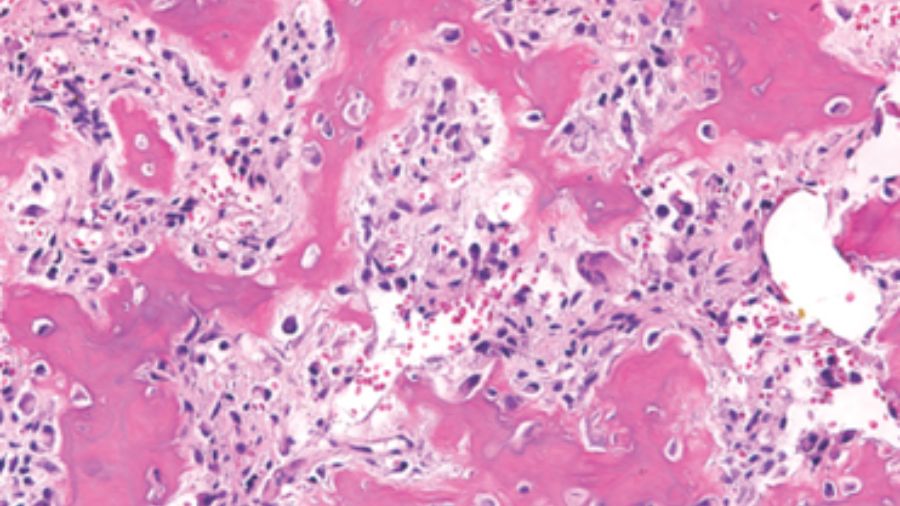

Wolf in sheep’s clothing? How to assess aggressiveness of osteoblastomas of the spine
BY DR FENG WEI
I would like to tell you the story of a benign tumor which had a sheep-like look, but finally was as fierce as a wolf. It concerns a case from 13 years ago, in a 47-year-old man. He had a hard mass in the left of his neck for eight months, with mild neck pain. The CT showed a tumor involved from C2 to C4 segments. There was no spinal cord compression. A bone scan showed a very hot spot.
A CT-guided biopsy demonstrated it was osteoblastoma, so we did an intralesional tumor curettage, leaving a rim of bony shell in the surrounding area. The postoperative pathology confirmed it was osteoblastoma, with focal epithelioid morphology.
One year after the surgery, recurrence was diagnosed by CT scan. We gave him 40-Gy radiation. Then, at two-year follow-up, the patient presented with neck pain, and a CT showed the tumor had recurred and progressed.
So, we did the second intralesional tumor excision. Histopathology revealed epithelioid osteoblasts proliferated in sheets. Postoperative CT showed the recurrent lesion was excised grossly.
But one and a half years after the surgery, the tumor recurred again.
This time, after the tumor arteries embolization, a more aggressive tumor excision was undertaken with sacrificing the nerve roots. The postoperative pathology showed the tumor composed of abundant epithelioid osteoblasts, but no signs of malignant appearance. The postoperative CT and MRI showed the recurrent tumor was excised grossly.
Unfortunately, only one year after the surgery, the tumor recurred. This time, no more treatment was undertaken. Tumor progressed extensively. Three years after the third surgery, the patient died of airway obstruction.
There was no metastasis from the beginning to the end.
Understanding osteoblastoma
So, what is osteoblastoma? Is it a benign tumor? Is it aggressive? Can it be malignant? Or is it all of them?
Generally speaking, osteoblastoma is a benign tumor composed of osteoblasts producing osteoid and bone. More than 80% of patients are in the first third decades of life.
The spinal column and sacrum are involved in more than 40% of all lesions. 55% of lesions are contained in posterior elements, and 42% affect both the posterior element and the adjacent vertebral body.
The most common symptoms are pain and signs of nerve root and spinal cord compression.
The osteoblastoma is a roundish osteolytic tumor, containing osseous-type mineralization. Its size varies from 1.5 cm to about 10 cm. Its margins are often well demarcated by a rind of bone sclerosis. The isotope bone scan is very hot.
In terms of histopathology, the tumor consists of large osteoblasts producing osteoid and woven bone.
Patients with osteoblastoma can present different biologic behavior and natural history, so it is important to predict the aggressive course, to make the right surgical decision.
Dorfman and Weiss proposed the conception of aggressive osteoblastoma, which represented a borderline lesion between benign osteoblastoma and osteosarcoma. These tumors were likely to recur but never metastasize. They occurred in an older group, mainly in the spine, and often larger than 4cm in diameter. However, the most prominent feature is the presence of so-called epithelioid osteoblasts.
Do epithelioid osteoblasts tell us this is a wolf?
There has always been controversy of epithelioid osteoblasts as an indicator of tumor aggressiveness.
Bertoni stated that epithelioid osteoblasts suggest a more aggressive lesion, thereby agreeing with the concept of aggressive osteoblastoma. On the other hand, Della, Lucas and Zon Filippi could not find any correlation between the morphologic appearance and its clinical behavior in their research.
In Lucas’ 306 cases series, there were 30 epithelioid osteoblastomas. The imaging can be clearly benign or aggressive. The results showed they were not more likely to recur even with intralesional excision. So, they concluded that the presence of epithelioid osteoblast alone was not a reliable predictor of aggressive behavior.
Schajowics and Lemos addressed a concept of ‘malignant osteoblastoma.’ They reported eight cases. They presented the characteristic features of genuine osteoblastoma but of an aggressive pattern, histologically resembling osteosarcoma. These had much better prognosis, only locally aggressive and no metastasis.
There is another aggressive variant, malignant transformation, which means the osteoblastoma, though histologically benign at the beginning, finally underwent a malignant transformation to high-grade osteosarcoma. Lucas reported two cases, but Campanacci denied this definition or concept. He believed the cases should be regarded as osteosarcoma in the beginning, which had not been recognized.
Introducing molecular diagnostics
From the above literature we can see that morphological pathology studies sometimes make it difficult to identify osteoblastoma and osteosarcoma. With the development of molecular diagnostics, the above situation has changed.
FOS is a member of the activated protein-1 family of transcriptions factors expressed in osteosarcoma. FOS rearrangement was found in osteoblastoma and osteoid osteoma, but not osteosarcoma. In 337 cases researched, most cases of osteoblastoma and osteoid osteoma showed significant expression of c-FOS, while very few c-FOS expressions showed in osteosarcoma. So, they concluded that the FOS gene rearrangement evaluation with immunohistochemistry was a valuable tool to differentiate osteoblastoma from osteosarcoma.
Right now, we can use modern molecular techniques to rule out osteosarcoma. We also know that it is difficult to use histological morphology to predict the aggressiveness of osteoblastoma. So, what can we rely on to predict the aggressiveness of osteoblastoma?
Boriani reported 51 cases of osteoblastoma to understand the role of Enneking staging system in identifying the aggressiveness of osteoblastoma.
Stage 2 lesions are lesions with well-defined borders, surrounding an ossified core, small diameter, and slow clinical course, and the lesion does not infiltrate the soft tissues.
Stage 3 lesions are defined as fully lytic images, eroding the cortex, and invading the surrounding soft tissues or canal. The margins are not well defined, and the clinical course is faster.
The results show no recurrence in stage 2. All recurrence occurred in stage 3. Five occurred in intralesional excision, and two in intralesional en bloc resection. No recurrence occurred in intralesional excision with radiotherapy and marginal or wide en bloc excision.
So, they concluded that the Enneking staging system is a valuable tool to identify the aggressiveness of osteoblastoma to select the appropriate treatment. Intralesional excision proved effective in stage 2 lesions and en bloc resection in stage 3. Intralesional excision can be combined with radiation therapy when wide margin en bloc resection is not feasible or when it is associated with unacceptable morbidity.
The best we can, with what we know
Let’s consider another case. It was a 55-year-old male presenting with incomplete paralyzed, Frankel C. Osteoblastoma of T12 was diagnosed by biopsy. It was Enneking stage 3 lesion. We did an intentional intralesional en bloc spondylectomy, then radiotherapy after the surgery. There was no recurrence in the two-year follow-up.
But sometimes things are more complicated. Another case involved a 33-year-old female. The chest X-ray examination found an osteogenic spinal lesion. The CT scan showed osteolytic lesions of T9 left vertebral body, facet joints and rib, with extensive reactive bone formation.
There was obvious spinal cord compression, and the PET/CT revealed extensive uptake.
We did a CT-guided biopsy. Although we consulted the result in three hospitals, the pathologists failed to give us a definite diagnosis, whether it was osteoblastoma or a low-grade osteosarcoma.
So, we treated it as if it was malignant. We did an anterior-posterior approach sagittal en bloc resection of the T8 to T10. In the anterior approach, we dissected the tumor. In posterior approach, we transected the body with an ultrasonic cutter. We resected three segments en bloc. The margin was sufficient, not only pathologically, but also by CT scan.
The postoperative pathological diagnosis is still unclear. The pathologists gave us four diagnoses: osteoblastoma, epithelioid osteoblastoma, low-grade osteosarcoma, or even osteomyelitis.
Nevertheless, the patient was doing well in the 2-year follow-up. There is no recurrence.
In another case, an 11 years-old girl was diagnosed with L5 osteoblastoma by CT guided biopsy. Because the tumor invaded the whole L5 vertebral body and the right facet joint and invaded posterior cortex into epidural space forming a soft tissue, it was diagnosed as Enneking S3.
The en bloc spondylectomy was undertaken by posterior approach. Postoperative gross specimen and pathological examination showed negative margin. The tumor showed no recurrence in the 2.5-year-follow-up.
There is always a distance between what we know and the truth. What we should do is the best we can with what we have.
About the author:
Dr Feng Wei is Associate Professor at the Orthopaedic Department of Peking University Third Hospital Beijing, China. His primary interest is in surgery of spine tumor and all kinds of degenerative spinal diseases.
References and further reading:
- Amary F, et al. FOS Expression in Osteoid Osteoma and Osteoblastoma: A Valuable Ancillary Diagnostic Tool. Am J Surg Pathol. 2019;43(12):1661-1667
Bertoni, et al. The morphologic spectrum of osteoblastoma (OBL): is its ‘aggressive’ nature predictable? Mod Pathol. 1993; 7:6A - Boriani S, et al. Staging and treatment of osteoblastoma in the mobile spine: a review of 51 cases. Eur Spine J. 2012 Oct;21(10):2003-10. doi: 10.1007/s00586-012-2395-8
- Della,et al. Osteoblastoma: do histologic features predict clinical behavior? A study of 55 patients. Mod Pathol. 1994; 7:6A.
- Filippi, et al. Epithelioid multinodular osteoblastoma: a clinicopathologic analysis of 26 cases. Am J Surg Pathol. 2007 Aug;31(8):1265-8.
- Lucas, et al. Osteoblastoma: a clinicopathologic study of 306 cases. Hum Pathol. 1994; 25:117–134.
- Schajowicz F, Lemos C. Malignant osteoblastoma. J Bone Joint Surg Br 1976; 58:202–11.
You could also be interested in:
Video lectures by AO Spine Knowledge Forum Tumor
This article is part of a series of lectures by the AO Spine Knowledge Forum Tumor.
Targeted therapies in cancer treatment
AO Spine Guest Blog article by Dr Chetan Bettegowda.
AO Video Hub
A vast collection of recorded lectures and webinars are available in the AO Video Hub for AO members.
AO Spine Knowledge Forum Tumor
International group of dedicated spine oncology surgeons and oncologists leading the way in spine oncology research.
Disclaimer
The articles included in the AO Spine Blog represent the opinion of individual authors exclusively and not necessarily the opinion of AO Spine or AO Foundation.